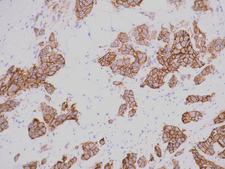
breastmalignanther2Vranic001.jpg

Decoding Disease: The Power of Advanced Microscopy Techniques
In this installment of the Science Literacy Series, Jacob Rose, from the Buck Institute on Aging, dives into the fascinating world of microscopy, charting its evolution from a simple tool for viewing thin tissue sections to a powerful instrument capable of illuminating complex cellular interactions. He explores how innovative staining techniques and fluorescence microscopy are revolutionizing our understanding of diseases, particularly cancer, and guiding the development of targeted treatments. This article aims to simplify the understanding of these advanced microscopy techniques and highlight their critical role in diagnosing diseases and conducting research.
science
9 mins
By: Jacob Rose
Microscopes are indeed among the most indispensable instruments in scientific and medical fields, serving as an essential tool for detailed examination of physical structures and properties at a microscopic level. They come in numerous forms, including optical microscopes, electron microscopes, and scanning probe microscopes. Each type is designed for specific uses and applications, but they all have a common goal: to reveal the structural or "morphological" characteristics of various samples, extending our ability to perceive beyond the limits of the naked eye.
These samples can be astonishingly diverse, ranging from solid tumor biopsies and tissue sections to cultured cells and basic blood smears. To put it into context, biopsies of solid tumors can provide critical insights into the nature of cancerous cells, aiding in accurate diagnosis and effective treatment planning. Tissue sections, on the other hand, can allow scientists to study the organization and function of various cell types in a specific organ, giving crucial knowledge about diseases and potential therapeutic strategies.
Cultured cells represent another significant type of sample. They are often used in research for understanding cell behavior, testing drug responses, and even for producing biological products. Blood smears, on the other hand, are fundamental in clinical diagnostics, aiding in the identification of blood disorders, infections, and certain types of cancer.
Tissue Staining
The process of preparing these samples often involves the creation of extremely thin sections or slices of the material, a technique known as "sectioning." For instance, a solid tissue specimen is carefully sliced into razor-thin sections, which are then placed onto a glass slide. This slide serves as a platform for further processing and microscopic examination.
It's worth mentioning that these samples, while revealing in their natural state, are often made more informative through a process called "staining." This involves using specific dyes that bind to particular molecules and cell structures, effectively making certain aspects of the sample stand out under microscopic observation. Staining techniques can highlight elements such as proteins, DNA, or different types of cells, offering a more in-depth look at the sample's composition. This considerably enhances our ability to understand, diagnose, and ultimately treat various diseases at a cellular level.
Tissue staining is an essential technique used in histology - the study of tissue under a microscope. Hematoxylin and Eosin (H&E), in particular, is the most commonly used stain in medical diagnosis, known as the gold standard. Hematoxylin, a basic dye, stains acidic (or basophilic) structures a purplish-blue color, which primarily include cell nuclei. Eosin, on the other hand, is an acidic dye and stains basic (or acidophilic) structures a pinkish-red color, primarily the cytoplasm and some other extracellular elements.
The combination of these two dyes provides a stunning contrast between different cellular and tissue components. The variations in shades of pink and purple enable a trained pathologist to discern a wealth of information about the tissue structure, its health, and potentially, disease presence.
Take the retina as an example - it's a multilayered structure located at the back of the eye, consisting of various types of cells, including photoreceptor cells (rods and cones), bipolar cells, and ganglion cells. When a retina section is stained with H&E, the distinct layers, and structures become easily identifiable due to the contrasting staining of different cells. The colors effectively outline the cellular architecture, highlighting the distribution, density, and organization of different cell types.

Retina microscopy
Importantly, any deviation from the normal cellular pattern can be a sign of disease. For instance, if a pathologist detects an abnormal proliferation of a particular cell type, it could indicate a pathological condition like retinal degeneration or even cancer. Such observations are fundamental for clinicians to make accurate diagnoses and formulate effective treatment plans.
Pathologists have the intricate task of interpreting cellular landscapes, differentiating between normal and abnormal tissues, and determining the severity of the disease based on certain "cellular landmarks."
In the context of breast cancer, for instance, pathologists look for changes in specific tissues like ductal or lobular tissue, the two types of tissues where most breast cancers begin. Normal breast tissues have a well-structured arrangement, with cells organized in specific patterns. In contrast, cancerous tissues often display disorganized cell structures, with abnormal cell shapes, sizes, and arrangements.

DCIS
For example, in ductal carcinoma in situ (DCIS), a non-invasive form of breast cancer, abnormal cells are found inside the milk ducts, but they haven't spread beyond these ductal structures. If these abnormal cells have invaded the surrounding breast tissue, it's termed invasive ductal carcinoma (IDC), which can be more aggressive. The location, quantity, and nature of these abnormal cells provide valuable information about the stage and grade of the cancer.
While Hematoxylin and Eosin (H&E) staining often provides enough data for a preliminary diagnosis, more detailed investigations may require additional markers, particularly when dealing with cancer. Cancer isn't a uniform disease; there are numerous subtypes, each with unique characteristics that may respond differently to various treatments.
Specifically, some breast cancers overexpress a protein called HER2 (human epidermal growth factor receptor 2). These HER2+ cancers tend to grow and spread more aggressively, but they can be specifically targeted by drugs like Herceptin that interfere with the HER2 protein.
If a pathologist suspects the presence of HER2+ breast cancer, they might recommend further tests to confirm the presence of HER2 receptors. This kind of personalized diagnostic approach helps tailor treatment to the individual's specific cancer type, improving the chances of successful treatment.
Immunohistochemistry
To delve deeper into the genetics and molecular biology of a given tissue, specialized techniques like in situ hybridization (ISH) and immunohistochemistry (IHC) are used. ISH is a method that identifies specific DNA or RNA sequences within the tissue, whereas IHC is used to detect specific proteins.
Both these techniques involve staining targeted molecules a brownish color, making them visible under a light microscope. In the context of HER2, a protein that resides on the cell membrane, an IHC test would stain the cell membranes brown if the HER2 receptor is present. Both DNA probes used in ISH and antibodies used in IHC are designed to bind to distinct segments of the gene or protein sequence, providing a precise snapshot of molecular activity in the tissue sample.
Breast Malignancy HER2+
Clinical labs typically have a set of tested and approved molecules and stains that assist in diagnosing various diseases. However, an official diagnosis often requires multiple stains to ensure the most accurate and comprehensive information regarding the identity of the cancer. This is because different stains highlight different aspects of cellular structure and function, providing a more holistic picture of the disease.
It's essential to note that the labs performing these clinical tests adhere to strict protocols and standards, resulting in exceptionally consistent and reliable results. The workflows in these settings are far more standardized and stringently regulated than those in research labs, ensuring the high quality of diagnostic data.
That being said, the techniques used in discovery research share much common ground with those in clinical labs, but their application can be far more complex and diverse. Researchers often combine various methods to answer complex biological questions, uncover novel insights, and develop new therapeutic approaches. The multifaceted nature of this work is what drives innovation in understanding and treating diseases like cancer.
Fluorescent Microscopy
Fluorescent microscopy, one of the most widely utilized techniques in both research and clinical labs, allows the detailed visualization of specific cellular molecules like proteins, DNA, and RNA. Unlike traditional "brightfield" microscopy, this technique uses fluorescent dyes, also known as fluorophores, that bind to specific molecules and are activated by a particular wavelength of light.
The principle of fluorescent microscopy lies in the unique property of fluorophores - they absorb light at one wavelength (the excitation wavelength) and then emit light at a longer wavelength (the emission wavelength). The result is an image with a black background and brightly colored signals from the activated probes, like this example of a blood vessel in a pig skin section.

fluorescent microscopy blood vessels
Typically, labs will use multiple fluorophores that emit light at different wavelengths, enabling simultaneous visualization of several target molecules in various colors. For instance, in an immunofluorescence experiment, different fluorophores might be used to study whether two proteins come together under specific conditions, and whether their cellular locations change when they do. These fluorophores, excited at distinct wavelengths (like 488nm for green and 555nm for red), generate separate color signals, reducing the chance of cross-activation and ensuring clarity in the experimental results.
Additional staining for cellular structures, like the blue fluorescent dye often used for staining nuclei, provides crucial context for these protein-protein interactions. If green and red signals overlap (colocalize) in the presence of specific conditions but not in control conditions, this suggests the proteins are interacting under the experimental conditions.
Analyzing how proteins move around the cell also necessitates staining for relevant cellular landmarks, such as the nucleus or mitochondria. If a protein's signal overlaps with the signal from a nuclear or mitochondrial stain, this provides compelling evidence that the protein functions within these organelles under certain conditions.
Advanced Techniques
While most labs can conduct experiments with three or four fluorescent markers, some specialized labs, like the Nolan Lab at Stanford, have taken this technique to another level. They employ advanced methods that utilize a coordinated system of "washable" dyes, allowing them to visualize more than 50 markers on a single tissue slide. This dramatically enhances the breadth of cellular phenomena that can be studied, from cell identity and inflammatory response to cancer progression, which dramatically boost interactions in cell interactions.
For instance, research from the Nolan lab is revealing how cells within specific tissue microenvironments interact on a molecular level, answering complex questions about cell identity changes over time or in disease contexts.
You can imagine that this technique gives incredible depth to a single tissue donation and dramatically increases the types of questions you can confidently answer. This extra power and confidence are exactly the type of information needed to improve the quality of care, diagnosis, prevention, and treatment for diseases, especially cancer.
Conclusion
Clearly, the microscope is a broadly applicable tool to both diagnose and investigate. The capabilities of this instrument are only increasing as we invent more techniques to multiply the dyes and stains available on one tissue section. Powerful microscopy techniques can bolster the information from a single tissue donation and will lead to more robust conclusions allowing us to more effectively and specifically treat multi-faceted diseases like cancer.
Understanding primary scientific literature can be a daunting task, but breaking up the techniques and applications into bite-sized chunks like this will help transform those weird colored blobs on a white or black background into meaningful data that point to incredible scientific discovery.
TAKE HOME POINTS
Microscopy techniques provide spatial information about a sample.
Spatial techniques are important to prove interactions between certain molecules or cells take place, and in what contexts those interactions are most important.
Most labs use stains and probes to visualize molecules of interest in their samples including DNA, RNA, and proteins.
Highly specialized labs are pushing the boundaries of microscopy and inventing ways to expand information garnered from a single sample.
Latest Longevity Research Straight to your Inbox
Sign up for The Longevity Blueprint, a weekly newsletter from Healthspan analyzing the latest longevity research.





